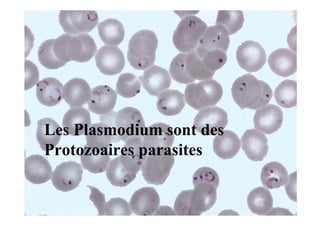
Les Plasmodium sont des
          Protozoaires parasites
Les Plasmodium sont des
Protozoaires parasites
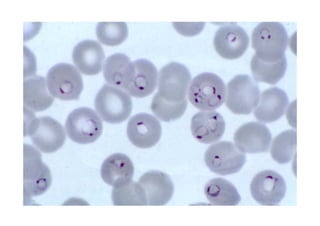
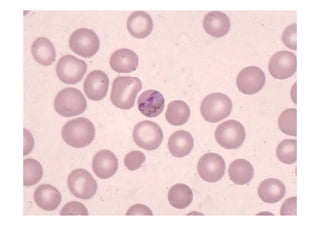
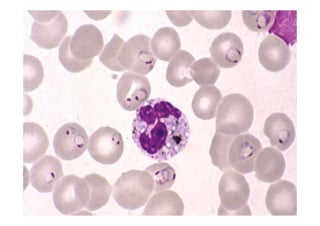

Le document traite des plasmodium, des protozoaires responsables du paludisme, en détaillant les différentes espèces affectant l'homme et leur cycle de vie complexe. Il souligne l'importance de reconnaître les espèces, critique l'efficacité des bandelettes de test par rapport à la microscopie, et aborde les caractéristiques des globules rouges affectés par les plasmodium. Enfin, il évoque les possibilités d'évolution des traitements médicamenteux en lien avec le métabolisme de l'hémoglobine.